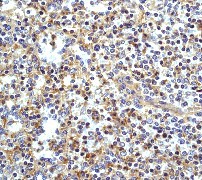

> Antigen, Antibodies, ELISA, Western Blot > Primary Antibody > Monoclonal Antibodies > HIAP-1 (BIR3) AntibodyBrand |
Leading Biology | Catalog Number |
APR07740G |
Product Type |
Monoclonal Antibodies | Field of Research |
|
Product Overview |
We constantly strive to ensure we provide our customers with the best antibodies. As a result of this work we offer this antibody in purified format.
We are in the process of updating our datasheets. If you have any questions regarding this update, please feel free to contact our technical support team.
This product is a high quality HIAP-1 (BIR3) antibody.
|
||
Molecular Weight |
68372 Da
|
||
Cellular Localization |
Antigen Cellular Localization:
Cytoplasm. Nucleus
|
||
Host |
Rabbit
|
||
Species Reactivity |
Human, Rat
|
||
Target |
A synthetic peptide corresponding to residues, before the breakpoint for translocation to form BIRC3-MALT1, of Human BIP3 was used as immunogen. The antibody does not cross-react with other IAP family members.
|
||
Clone |
E40
|
||
Symbol |
API2, IAP1, MIHC, RNF49
|
||
GeneID |
|||
UniProt ID |
|||
Function |
Multi-functional protein which regulates not only caspases and apoptosis, but also modulates inflammatory signaling and immunity, mitogenic kinase signaling and cell proliferation, as well as cell invasion and metastasis. Acts as an E3 ubiquitin- protein ligase regulating NF-kappa-B signaling and regulates both canonical and non-canonical NF-kappa-B signaling by acting in opposite directions: acts as a positive regulator of the canonical pathway and suppresses constitutive activation of non-canonical NF-kappa-B signaling. The target proteins for its E3 ubiquitin- protein ligase activity include: RIPK1, RIPK2, RIPK3, RIPK4, CASP3, CASP7, CASP8, IKBKE, TRAF1, and BCL10. Acts as an important regulator of innate immune signaling via regulation of Toll-like receptors (TLRs), Nodlike receptors (NLRs) and RIG-I like receptors (RLRs), collectively referred to as pattern recognition receptors (PRRs). Protects cells from spontaneous formation of the ripoptosome, a large multi-protein complex that has the capability to kill cancer cells in a caspase-dependent and caspase- independent manner. Suppresses ripoptosome formation by ubiquitinating RIPK1 and CASP8.
|
||
Summary |
cIAP-2, also known as HIAP-1, is a member of the inhibitor of apoptosis (IAP) family of proteins. These proteins contain a BIR (baculovirus IAP repeat) domain near the amino-terminus (1). cIAP-2 is localized to the cytoplasm. The BIR motifs region interacts with TNF receptor associated factors 1 and 2 (TRAF1 and TRAF2) to form a heteromeric complex, which is then recruited to the tumor necrosis factor receptor 2 (TNFR2). This complex is thought to play a role in inhibition of apoptosis (2,3). cIAP-2 inhibits cytochrome c-induced activation of caspase-9, thereby preventing initiation of the caspase cascade and apoptosis (4).
|
||
Form |
50 mM Tris-Glycine (pH 7.4), 0.15 M NaCl, 40% Glycerol, 0.01% sodium azide and 0.05% BSA. |
||
Storage & Stability |
Store at +4°C short term. For long-term storage, aliquot and store at -20°C or below. Stable for 12 months at -20°C. Avoid repeated freeze-thaw cycles.
|
||
Applications |
WB, IHC
|
||
Dilution |
WB~~1:5000
IHC~~1:50
|
||
Synonyms |
Baculoviral IAP repeat-containing protein 3, 632-, Apoptosis inhibitor 2, API2, C-IAP2, IAP homolog C, Inhibitor of apoptosis protein 1, IAP-1, hIAP-1, hIAP1, RING finger protein 49, TNFR2-TRAF-signaling complex protein 1, BIRC3, API2, IAP1, MIHC, RNF49
|
||
Images |

A. Western blot analysis on Daudi cell lysate using anti-HIAP-1/BIR3 RabMAb (Cat. APR07740G), dilution 1:1,000.
B. Immunohistochemical analysis of human normal spleen using anti-HIAP-1/BIR3 RabMAb (Cat. APR07740G). |
||
Specification |
|||
Quantity |
|
||
| Select | Brand | Catalog No. | Product Name | Pack Size | Type | Field of Research | Specification | Quantity | Price(USD) | |
| 1 | Leading Biology | APG02467G | CCK4 / PTK7 Antibody (clone 4F9) | 50 μl | Monoclonal Antibodies |
|
$495.00 | Add Ask | ||
| 2 | Leading Biology | AMM04683G | GALT Antibody (clone 4C11) | 50 μg | Monoclonal Antibodies |
|
$545.00 | Add Ask | ||
| 3 | Leading Biology | AMM01402G | Vimentin (Mesenchymal Cell Marker) Antibody - With BSA and Azide | 50 ug | Monoclonal Antibodies |
|
$395.00 | Add Ask | ||
| 4 | Leading Biology | APR08280G | LTA4H / LTA4 Antibody (clone 9G8) | 50 μl | Monoclonal Antibodies |
|
$495.00 | Add Ask | ||
| 5 | Leading Biology | AMM00172G | CD1a / HTA1 (Mature Langerhans Cells Marker) Antibody - With BSA and Azide | 50 ug | Monoclonal Antibodies |
|
$395.00 | Add Ask | ||
| 6 | Leading Biology | AMM05750G | CEBPA Antibody | 100 μl | Monoclonal Antibodies |
|
$545.00 | Add Ask |
 Leading Biology Inc.
2600 Hilltop DR, Building G, B Suite C138
Richmond, CA, 94806
Tel: 1-661-524(LBI)-0262
Email: info@leadingbiology.com
Leading Biology Inc.
2600 Hilltop DR, Building G, B Suite C138
Richmond, CA, 94806
Tel: 1-661-524(LBI)-0262
Email: info@leadingbiology.com
Complete this form and click send to ask us a question, request a quote or simply say hello.

You have 0 item in your cart

You have 0 item in your inquiry list
